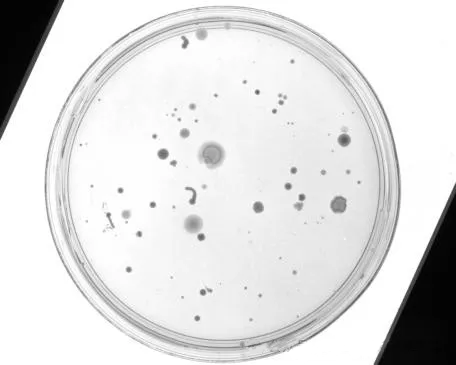

熱線電話:0755-23712116
郵箱:contact@shuangyi-tech.com
地址:深圳市寶安區(qū)沙井街道后亭茅洲山工業(yè)園工業(yè)大廈全至科技創(chuàng)新園科創(chuàng)大廈2層2A
機(jī)器視覺(jué)系統(tǒng)中的光源是實(shí)現(xiàn)高質(zhì)量圖像捕獲的關(guān)鍵組件。適當(dāng)?shù)墓庠床粌H能夠改善圖像的質(zhì)量,還能影響視覺(jué)系統(tǒng)的檢測(cè)效率和精確度。選擇合適的光源,可以顯著提高系統(tǒng)的整體性能,簡(jiǎn)化圖像處理過(guò)程,并提高檢測(cè)的準(zhǔn)確性。

不同光源下的拍攝情況
不同的光源產(chǎn)生了完全不同的成像效果,從而也導(dǎo)致不同的檢測(cè)算法
光源的影響
光源的選擇直接影響到機(jī)器視覺(jué)系統(tǒng)的圖像成像質(zhì)量和效果。如圖所示,不同的光源可以產(chǎn)生不同的成像效果,這將進(jìn)一步影響檢測(cè)算法的選擇和優(yōu)化。例如,使用不同顏色和強(qiáng)度的光源可以突出某些特征或隱藏不相關(guān)的細(xì)節(jié),從而簡(jiǎn)化算法處理需求。


紅色的光源過(guò)濾掉紅色的文字
案例分析
在實(shí)際應(yīng)用中,根據(jù)任務(wù)的具體需求選擇合適的光源至關(guān)重要。例如,在檢測(cè)具有復(fù)雜表面特征的物體時(shí),選擇合適的光源可以顯著提高對(duì)比度和識(shí)別率。在一項(xiàng)涉及金屬部件檢測(cè)的案例中,通過(guò)使用特定波長(zhǎng)的光源,能夠減少表面反射帶來(lái)的干擾,提高檢測(cè)的準(zhǔn)確性。



瓶蓋上面是黑色,另有紅黑交錯(cuò)背景圖案,條碼為激光刻印顯灰色,為了顯現(xiàn)出條碼,應(yīng)該將字符打亮,背景與字符分辨明顯;我們?nèi)绻x用紅色光源的話,背景中的紅色會(huì)濾掉打白,會(huì)干擾同為白色的字符,所以,我們應(yīng)該利用光源的互補(bǔ)原理,采用藍(lán)色光源,將紅色背景盡量打黑;
結(jié)論
正確的光源選擇對(duì)于機(jī)器視覺(jué)系統(tǒng)的成功至關(guān)重要。它不僅影響成像質(zhì)量,還直接影響到系統(tǒng)的穩(wěn)定性和可靠性。通過(guò)實(shí)際案例的分析,我們可以看到合適的光源選擇能夠極大地優(yōu)化視覺(jué)系統(tǒng)的性能,這對(duì)于高精度和高效率的視覺(jué)檢測(cè)系統(tǒng)是必不可少的。
熱線電話:0755-23712116
郵箱:contact@shuangyi-tech.com
地址:深圳市寶安區(qū)沙井街道后亭茅洲山工業(yè)園工業(yè)大廈全至科技創(chuàng)新園科創(chuàng)大廈2層2A


